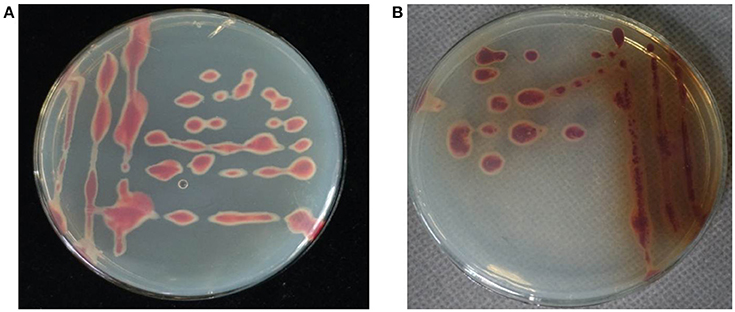

- 1Plant Protection Research Institute Guangdong Academy of Agricultural Sciences, Guangzhou, China
- 2Guangdong Provincial Key Laboratory of High Technology for Plant Protection, Guangzhou, China
Ralstonia solanacearum species complex is a devastating phytopathogen with an unusually wide host range, and new host plants are continuously being discovered. In June 2016, a new bacterial wilt on Cucurbita maxima was observed in Guangdong province, China. Initially, in the adult plant stage, several leaves of each plant withered suddenly and drooped; the plant then wilted completely, and the color of their vasculature changed to dark brown, ultimately causing the entire plant to die. Creamy-whitish bacterial masses were observed to ooze from crosscut stems of these diseased plants. To develop control strategies for C. maxima bacterial wilt, the causative pathogenic isolates were identified and characterized. Twenty-four bacterial isolates were obtained from diseased C. maxima plants, and 16S rRNA gene sequencing and pathogenicity analysis results indicated that the pathogen of C. maxima bacterial wilt was Ralstonia solanacearum. The results from DNA-based analysis, host range determination and bacteriological identification confirmed that the 24 isolates belonged to R. solanacearum phylotype I, race 1, and eight of these isolates belonged to biovar 3, while 16 belonged to biovar 4. Based on the results of partial egl gene sequence analysis, the 24 isolates clustered into three egl- sequence type groups, sequevars 17, 45, and 56. Sequevar 56 is a new sequevar which is described for the first time in this paper. An assessment of the resistance of 21 pumpkin cultivars revealed that C. moschata cv. Xiangyu1 is resistant to strain RS378, C. moschata cv. Xiangmi is moderately resistant to strain RS378, and 19 other pumpkin cultivars, including four C. maxima cultivars and 15 C. moschata cultivars, are susceptible to strain RS378. To the best of our knowledge, this is the first report of C. maxima bacterial wilt caused by R. solanacearum race 1 in the world. Our results provide valuable information for the further development of control strategies for C. maxima wilt disease.
Introduction
Bacterial wilt, which is caused by the Ralstonia solanacearum species complex (RSSC), is one of the most important and devastating plant diseases in the tropics, subtropics and other warm temperate areas of the world (Hayward, 1991). Ralstonia solanacearum has a very wide plant host range—more than 200 plant species belonging to over 50 botanical families (Denny, 2006). Traditionally, R. solanacearum has been divided into five races based on host range (Buddenhagen et al., 1962; Pegg and Moffett, 1971; He et al., 1983), and six biovars have been described based on their ability to oxidize three disaccharides and three hexose alcohols (Hayward, 1964, 1991, 1994; He et al., 1983).
Recently, molecular methods have resulted in a greater understanding of the diversity of R. solanacearum. Cook et al. (1989) and Cook and Sequeira (1994) distinguished 46 multilocus genotypes of R. solanacearum by restriction fragment length polymorphism (RFLP) analysis and clustered R. solanacearum strains into two divisions, division I and division II. Division I includes biovar 3, 4, and 5 strains originating from Australia and Asia, and division II includes biovar 1, 2, and 2T strains originating from the Americas. Two more groups of strains were identified by fingerprinting analyses using amplified fragment length polymorphism (AFLP) and polymerase chain reaction-RFLP (PCR-RFLP) techniques on targeting the HRP cluster gene (Poussier et al., 2000a), 16S rRNA gene (Li et al., 1993; Taghavi et al., 1996; Poussier et al., 2000a), intergenic spacer region between the 16S and 23S rRNA genes (ITS), and endoglucanase and hrpB genes (Fegan et al., 1998; Poussier et al., 2000b). One group includes biovar 1 and 2T strains from Africa, and another group includes strains belonging to biovars 1, 2, and 2T from Indonesia as well as two closely related strains of Ralstonia syzygii, a pathogen from cloves, and the bacterial agent of blood disease of banana (BDB) (Taghavi et al., 1996).
Ralstonia solanacearum is considered a “species complex” due to the significant genetic diversity that exists within the species, which was identified by Fegan and Prior (2005), who proposed a new hierarchical classification scheme for R. solanacearum. The R. solanacearum species complex comprises species, phylotypes, sequevars, and clones in this new hierarchical classification (Fegan and Prior, 2005). The phylotypes are defined into monophyletic clusters by phylogenetic analysis of the ITS region, hrpB gene and egl gene. Phylotypes I and II are equivalent to divisions I and II (Cook and Sequeira, 1994). Phylotype III contains strains from Africa. Phylotype IV contains strains from Indonesia as well as R. syzygii and BDB. These phylotypes are identified via multiplex PCR with R. solanacearum species-specific primers 759/760 and phylotype-specific primers (Nmult:21:1F, Nmult:21:2F, Nmult:23:AF, Nmult:22:InF, and Nmult:22:RR). Strains of R. solanacearum, R. syzygii and BDB generate a species-specific 280-bp fragment with primers 759/760, and strains in phylotypes I to IV generate fragments of 144, 372, 91, and 213 bp, respectively, with the phylotype-specific primers. Phylotypes are subdivided into sequevars based on the analysis of partial egl gene sequences and into clones by genetic fingerprinting techniques such as pulsed field gel electrophoresis (PFGE) and repetitive-sequence-based polymerase chain reaction (rep-PCR) (Fegan and Prior, 2005). To date, 55 sequevars of R. solanacearum have been identified (Li et al., 2016; Liu et al., 2017). Furthermore, based on a polyphasic taxonomic approach that emphasizes DNA-DNA hybridization analysis, the R. solanacearum species complex comprises three genospecies (Safni et al., 2014). Safni et al. suggested that R. pseudosolanacearum sp. nov. corresponds to phylotypes I and III, R. solanacearum corresponds to phylotype II, and R. syzygii corresponds to phylotype IV (Safni et al., 2014). According to an analysis of genotypic and phenotypic data and genomic sequences, Safni et al. also suggested that R. syzygii be divided into three subspecies: R. syzygii subsp. syzygii subsp. nov., which corresponds to the current R. syzygii strains; R. syzygii subsp. indonesiensis subsp. nov., which corresponds to the current R. solanacearum phylotype IV strains; and R. syzygii subsp. celebesensis subsp. nov., which corresponds to the BDB strains (Safni et al., 2014). In 2016, using a combination of phenotypic analyses, whole-genome comparisons and proteomic profiling, Prior et al. suggested that the R. solanacearum species complex be divided into three species: the first species includes phylotypes I and III, the second species corresponds to phylotype II, and the third species comprises the phylotype IV strains, R. syzygii, and the BDB strains (Prior et al., 2016).
Bacterial wilt is one of the most important crop diseases, especially in southern China, and it was first observed in peanuts in the early 1930s (Ma and Gao, 1956). Later, this disease was reported in sweet potatoes (Ipomoea batatas (L.) Lam) (Zheng and Fan, 1962), horsetail beefwood (Casuarina equisetifolia L.), mulberry (Morus alba L.) and eucalyptus (Eucalyptus spp.) (He et al., 1983; He, 1985). Over time, even more hosts were found to be susceptible to R. solanacearum infection. In China, more than 28 host plants of R. solanacearum have been reported within the past decade (He et al., 2008; Liu et al., 2009; Wang et al., 2009; Xu et al., 2009; She et al., 2012, 2013), and new host plants are continuously being discovered. In June 2016, Cucurbita maxima bacterial wilt was first observed in a field in Guangzhou City, Guangdong province, China. The plant symptoms of C. maxima bacterial wilt are similar to those of other host plants bacterial wilt. We obtained 24 bacterial isolates from diseased plants of C. maxima and conducted the present study to identify the causal agent of C. maxima bacterial wilt.
Materials and Methods
Symptoms
Disease development in C. maxima begins with drooping of the half side of the top leaf (Figure 1A) and continues with lower leaf wilt and droop, whole plant wilt (Figure 1B), changes in the color of the vasculature to dark brown (Figure 1D), and death of the plant (Figure 1C). These symptoms are similar to those caused by R. solanacearum in other host plants. Bacterial oozing from the stem crosscut sites of plants infected with R. solanacearum was observed (Figure 1E).

Figure 1. Top leaf stunting (A), wilting plants (B), and plant death (C) of C. maxima in fields; (D) vascular discoloration of a C. maxima stem infected with R. solanacearum; (E) bacteria oozing from the crosscut site of a C. maxima stem; and (F) inoculated plants showing wilt symptoms in a greenhouse.
Pathogen Isolation
To isolate the putative causative agent from diseased plants, 24 wilted plants of C. maxima were collected from fields in the Baiyun district in Guangzhou City, Guangdong province, China. An approximately 1.5 × 0.5 cm section of the basal stem from each diseased plant was excised, surface-sterilized with 70% (v/v) ethanol for 30 s and 0.5% (v/v) sodium hypochlorite for 30 s, and then rinsed with sterile water 4–6 times. An approximately 0.5 × 0.5 mm section of vascular tissue from the surface-sterilized stem section was mashed and macerated in 50 μl of sterile distilled water and left to stand for 2–3 min. These suspensions were then streaked on 2,3,5-triphenyltetrazolium chloride (TZC) medium plates (Kelman, 1954) and incubated at 30°C for 2 days. Large, irregular, round, fluidal and white colonies with pink center pre-dominated the TZC medium plates. One isolate was obtained from each plate after two successive single-colony isolations. In all, 24 isolates were stored in 15% (w/v) glycerol at −80°C for further use.
Pathogenicity Analysis
Virulence tests were performed on four- to six-leaf stage plants of C. maxima, tomato (Lycopersicon esculentum, cv. Dongqie), pepper (Capsicum annuum, cv. Yuejiao No. 15), eggplant (Solanum melongena, cv. Yuefeng), tobacco (Nicotiana tabacum), banana (Musa nana, cv. Dafeng No. 1) and ginger (Zingiber officinale). Fifteen plants of each host were inoculated with each isolate. Six of the seven hosts (excluding ginger), were inoculated by injuring the roots and soaking them in a bacterial suspension (1 × 108 cfu/ml) for 20 min. The roots of 15 plants of each host were also injured and soaked in fluid nutrient medium as negative controls. Fifteen ginger plants were inoculated by injection with 200 μl of a bacterial suspension (1 × 108 cfu/ml) in their stem bases. Fifteen additional ginger plants were injected with 200 μl of fluid nutrient medium as negative controls. After inoculation, the plants were incubated at 28–30°C and 75–80% relative humidity. Disease incidence (DI) was monitored every week for 5 weeks. Plants with visible symptoms (wilted leaves) were recorded as diseased plants. The disease incidence was calculated as DI (%) = 100 × number of disease plants/15 inoculated plants. The experiment was repeated three times. The bacterial pathogen was re-isolated from inoculated C. maxima plants exhibiting wilt symptoms.
DNA Preparation
DNA was extracted from each isolate using an EasyPure® Genomic DNA kit (TransBionovo Co., Ltd., China) according to the manufacturer's instructions, and the quality and quantity of the DNA samples were checked by measuring their A260/A280 ratios using a NanoDrop One Microvolume UV-Vis Spectrophotometer (Instrument operating software version 1.2.0, Thermo Fisher Scientific, Inc.). The DNA samples were stored at −20°C until use.
DNA Sequencing of the 16S rRNA Gene
The DNA samples were used as templates for PCR amplification of the 16S rRNA gene using the universal primers 27f/1491r (Woese et al., 1983). Approximately 50 ng of DNA template was added to 12.5 μl of Premix Taq™ (0.625 U of TaKaRa Taq, 0.2 mM dNTP mixture, PCR buffer, 10 mM Tris-HCl, pH 8.3, 50 mM KCl, and 1.5 mM MgCl2) (TaKaRa Biotechnology Co., Ltd, China), 10 pmoles of the primers 27f and 1491r (Woese et al., 1983) and ddH2O to a final volume of 25 μl. The PCR program consisted of an initial denaturation at 96°C for 5 min, followed by 35 cycles of 94°C for 1 min, 48°C for 1 min and 72°C for 3 min, and a final extension at 72°C for 10 min in a Mastercycler® Gradient Thermal Cycler (Eppendorf, Germany). The PCR product for each strain was subjected to electrophoresis on a 1% agarose gel at 100 V/cm for 40 min, which was then stained with DNA Green (TIANDZ, China) and visualized using a UV-transilluminator.
Each resulting amplicon was ligated into the vector pMD-20T (TaKaRa Biotechnology Co., Ltd, China). The 16S rRNA fragment-containing recombinant plasmids were transformed into Escherichia coli strain JM109. Three clones were randomly picked from each transformation and sequenced in both directions using primer walking (Invitrogen Life Technologies China Co., Ltd, China). The pathogens were identified by blasting the obtained 16S rRNA gene sequences against the NCBI database.
Biovar Determination
Biovars of the 24 isolates were determined as described by Hayward (1964). Briefly, 10 μl of a cultured bacterial suspension (1 × 108 cfu/ml) were stabbed into slants of Hayward's medium containing 1% filter-sterilized D-(+)-cellobiose, lactose, maltose, sorbitol, mannitol or dulcitol in glass tubes. All of the inoculated tubes were incubated at 30°C for 3 weeks. Each treatment was repeated three times. Liquid culture media inoculation was used as a negative control. Color changes of the Hayward's medium slants from green to yellow were recorded as positive.
Phylotype-Specific Multiplex PCR (Pmx-PCR) Amplification
The strain phylotypes was determined utilizing a phylotype-specific multiplex PCR (Pmx-PCR) assay following a previously described method (Fegan and Prior, 2005; Prior and Fegan, 2005). Approximately 50 ng of DNA template was added to 12.5 μl of Premix Taq™ (0.625 U of TaKaRa Taq, 0.2 Mm dNTP Mixture, PCR buffer, 10 mM Tris-HCl, pH 8.3, 50 mM KCl, and 1.5 mM MgCl2) (Takara Co.); 6 pmoles of the primers Nmult:21:1F, Nmult:21:2F, and Nmult:22:InF; 18 pmoles of the primer Nmult:23:AF; 4 pmoles of the primers 759 and 760 (Opina et al., 1997; Xu et al., 2009); and ddH2O to a final volume of 25 μl. The PCR program included an initial denaturation at 96°C for 5 min, followed by 30 cycles of 94°C for 15 s, 50°C for 30 s and 72°C for 30 s, and a final extension at 72°C for 10 min in a Mastercycler® Gradient Thermal Cycler (Eppendorf, Germany). Eight microliters of PCR product for each strain was subjected to electrophoresis on a 2% agarose gel at a voltage of 100 V/cm for 40 min, which was then stained with DNA Green (TIANDZ, China) and visualized using a UV-transilluminator.
Partial Sequencing of the Endoglucanase (egl) and hrpB Genes
PCR amplification of the 1,360-bp region of the egl gene was performed using the primers eglF (5′-TCTCCATTTTTCCATTTCGTCATG-3′) and eglR (5′-ATGCCATC CGCCACGGACCCGGC-3′). Approximately 50 ng of DNA template was added to 25 μl of Premix Taq™, 0.5 μM of each primer, 2 μl of dimethyl sulfoxide and ddH2O to a final volume of 50 μl. The PCR program included an initial denaturation at 96°C for 9 min, followed by 35 cycles of 94°C for 1 min, 62°C for 1 min and 72°C for 2.5 min, and a final extension at 72°C for 10 min in a Mastercycler® Gradient Thermal Cycler. PCR amplification of the 1,434-bp region of the hrpB gene was performed using the primers hrpBF (5′-TGACGCTTCAGGAGCATTGCC-3′) and hrpBR (5′-AGATGGGAAGGGAGAGGACC-3′). Approximately 50 ng of DNA template was added to 25 μl of Premix Taq™, 0.5 μM of each primer, 2 μl of dimethyl sulfoxide and ddH2O to a final volume of 50 μl. The PCR program included an initial denaturation at 96°C for 5 min, followed by 35 cycles of 94°C for 1 min, 62°C for 1 min and 72°C for 3 min, and a final extension at 72°C for 10 min using a Mastercycler® Gradient Thermal Cycler (Eppendorf, Germany). Six microliters of PCR product from each strain was subjected to electrophoresis on a 1% agarose gel at a voltage of 120 V/cm for 25 min, which was then stained with DNA Green and visualized using a UV-transilluminator. The PCR products were purified and sequenced by Shanghai Sangon Biological Engineering Technology & Service CO., Ltd. The PCR primers were also used as sequencing primers.
Sequence Analysis
Twenty-three sequences of the egl gene and 21 sequences of the hrpB gene were selected for analysis (Table 1). The sequences were edited with BioEdit 7.0.5.1 (Hall, 1999) and aligned using Clustal W in DNASTAR MegAlign software, version 5.01 (DNASTAR Inc., Madison, WI, USA). Phylogenetic trees were constructed using the neighbor-joining (NJ) and maximum-likelihood (ML) methods embedded in MEGA version 6.0 (Tamura et al., 2013). Bootstrapping was performed with 100 replicates for the ML tree and 1,000 replicates for the NJ tree. All of the egl and hrpB sequences from the R. solanacearum strains isolated in this study were deposited into GenBank (Table 1).
Evaluation of the Resistance of Pumpkin Cultivars to R. solanacearum
Twenty-one pumpkin cultivars, including four cultivars of C. maxima and 17 cultivars of C. moschata, were collected and used for resistance evaluation. Plants with four true leaves were inoculated by injuring the roots and soaking them in a bacterial suspension (1 × 108 cfu/ml of strain RS378) for 20 min. Inoculated plants were transplanted into plastic pots (9 cm in diameter) containing horticultural soil. This experiment included four plot experiments with 30 plants each. The DI was monitored every week for 5 weeks after inoculation. Plants with visible symptoms (leaf wilt) were recorded as diseased plants. The disease incidence was calculated as DI (%) = 100 × number of disease plants/total number of inoculated plants in each plot experiment (30). The DI ranged from 0 (no disease) to 100% (dead). Analysis of variance (ANOVA) was used to analyze the disease incidence data from each assessment using a Data Processing System (DPS) based on Duncan's new multiple range method (Hanzhou RuiFeng Information Technology Co., Ltd).
The resistance of the 21 pumpkin cultivars to strain RS378 was evaluated for 5 weeks after inoculation and categorized as follows: DI value of (i) 0–20.0%, highly resistant (HR); (ii) 20.1–40.0%, resistant (R); (iii) 40.1–60.0%, moderately resistant (MR); (iv) 60.1–80.0%, susceptible (S); and (v) 80.1–100%, highly susceptible (HS).
Results
Bacterial Isolation and Biovar Determination
Pure bacterial cultures were isolated on TZC medium plates from the basal stem tissues of C. maxima plants showing wilt symptoms. A total of 24 isolates were obtained. All of the isolates had irregular, round, fluidal, white colonies with pink center that predominated on TZC medium plates. However, 16 of the 24 isolates secreted a brown pigment after incubation at 30°C for 2 days (Figure 2). The phenotypic characterization for biovar determination revealed a predominance of biovar 4 strains over biovar 3 from C. maxima. Of the 24 tested isolates, eight isolates utilized maltose, lactose, D-(+)-cellobiose, mannitol, sorbitol and dulcitol and thus belonged to biovar 3, and 16 isolates secreted brown pigment on TZC medium and utilized mannitol, sorbitol and dulcitol but not maltose, lactose and D-(+)-cellobiose and thus belonged to biovar 4 (Table 1). No other biovars were found.
Figure 2. Morphology of R. solanacearum biovar 3 isolate RS348 (A) and biovar 4 isolate RS371 (B) on TZC medium plates.
Pathogen Identification
Using the universal PCR primers 27f and 1491r, each of the 24 isolates generated a 1,423-bp 16S rRNA gene fragment. BLAST analysis of these 16S rRNA gene sequences revealed that they shared 100% identity with R. solanacearum strain GMI1000 (GenBank accession no. AL646052). The 16S rRNA gene sequences of these isolates were deposited in GenBank under accession numbers KY594769 to KY594788 and KX363800 to KX363803. These results established that the isolates from the diseased C. maxima plants exhibiting wilt symptoms in Guangdong, China, were R. solanacearum.
Pathogenicity Test
One or two of the youngest leaves of the C. maxima plants inoculated with the R. solanacearum isolates began to successively exhibit wilting at 5 days post inoculation (dpi) (Figure 1F). The initial symptom in diseased plants was apical leave wilting during the day that recovered at night. Subsequently, the wilted leaves failed to recover at night, and the whole plant withered 3 days later. No symptoms were observed in the control plants. Pathogens with the same morphology on TZC medium plates as that of the bacterial isolates mentioned above were also re-isolated from the inoculated plants with wilt symptoms. Based on these results, the pathogen causing wilt in C. maxima was confirmed to be R. solanacearum.
Inoculated plants of tomato, eggplant and pepper began to wilt at 5 dpi. The number of wilted plants stabilized at 35 dpi. Statistical analysis revealed that all of the 24 isolates were pathogenic to tomato and eggplant, with disease incidences of 66.7–100%; to pepper, with disease incidences of 26.6–86.7%; and to tobacco and ginger, with disease incidences of 0–26.67%. These isolates were not pathogenic to banana at 35 dpi (Table 2).
Phylotyping and Phylogenetic Analysis
Using the Pmx-PCR protocol, each of the 24 isolates generated the expected 280-bp species-complex-specific fragment and a 144-bp fragment specific to phylotype I of R. solanacearum, suggesting that all of the isolates from C. maxima that cause wilting disease should be phylotype I strains.
Partial sequences of the egl and hrpB genes from these 24 isolates were analyzed. The egl gene sequences from the 24 isolates shared identities of 99–100% with each other. The hrpB gene sequences from the 24 isolates shared identities of 99.1–100% with each other. These sequences were deposited in GenBank under the accession numbers KY594789 to KY594812 for the egl gene and KY594813 to KY594836 for the hrpB gene. Phylogenetic trees were constructed using egl gene sequences of the 24 isolates from C. maxima and 23 reference strains and hrpB gene sequences of the 24 isolates from C. maxima and 21 reference strains of R. solanacearum, which were retrieved from GenBank. The reference strain sequences were added to the phylogenetic tree to position the strains in this study within the known phylogenetic structure (Liu et al., 2017). Two phylogenetic methods (NJ and ML) yielded similar results, but only the NJ tree is displayed for discussion. Based on the egl and hrpB trees, all of the 24 isolates in this study were classified into phylotype I, consistent with results from Pmx-PCR. The branching patterns in the egl and hrpB trees for phylotype I showed a split with 100 and 96% bootstrap values, respectively. In the egl tree, the 24 isolates clustered into three major groups, A, B and C. Group A, which includes 17 isolates, represented sequevar 45. Group B, which contains three isolates, was not identical to any previously designated sequevar and was thus defined as sequevar 56, a new sequevar. Group C, which included four isolates, represented sequevar 17 (Figure 3). Conversely, in the hrpB tree, the 24 isolates clustered into one group (Figure 4).

Figure 3. Phylogenetic analysis of 24 isolates from C. maxima and 23 related strains of R. solanacearum. The phylogenetic tree of egl gene partial sequences was constructed with MEGA 6.0 using the neighbor-joining method. The numbers at the tree branch points indicate the percent bootstrap support for 1,000 iterations.

Figure 4. Phylogenetic analysis of 24 isolates from C. maxima and 21 related strains of R. solanacearum. The phylogenetic tree of hrpB gene partial sequences was constructed with MEGA 6.0 using the neighbor-joining method. The numbers at the tree branch points indicate the percent bootstrap support for 1,000 iterations.
Resistance Assessment of Pumpkin Cultivars
Inoculated pumpkin plants began to wilt at 5 dpi. The number of diseased plants stabilized at 35 dpi. Statistical analysis revealed that none of the 21 pumpkin cultivars was immune to R. solanacearum strain RS378. The disease incidences for the 21 cultivars ranged from 38.63 to 94.92%. Xiangyu1, a C. moschata cultivar with a DI value of 38.63%, was resistant to strain RS378. Xiangmi, a C. moschata cultivar with a DI value of 57.88%, was moderately resistant to strain RS378. Seven C. moschata cultivars, including Xiangyu101, Pocket-size, C. moschata, Yuemei No. 1, Wushan, Super long pumpkin and Xiangyu2, had disease incidences ranging from 60.46 to 77.50% and were susceptible to strain RS378. Eight C. moschata cultivars, including Butternut squash, Jingou, Zhongnan, Jinling, Xiangmi-Xiangyu, Pumpkin King, Jinniu No. 3 and No. 3 had disease incidences that ranged from 81.50 to 94.92% and were highly susceptible to strain RS378. Four C. maxima cultivars, including Black rose 879, Longxindan, Jinhongxi889 and Red earth, had disease incidences ranging from 83.62 to 93.73% and were highly susceptible to strain RS378 (Table 3).

Table 3. Pathogenicity of strain RS378 of R. solanacearum on cultivars of C. maxima and C. moschata.
Discussion
A newly observed bacterial wilt disease in C. maxima in China is caused by R. solanacearum. In this study, a total of 24 isolates were obtained from C. maxima plants with bacterial wilt in Guangdong province, China, in 2016. These isolates produced typical R. solanacearum-type colonies on TZC medium plates (Figure 2). The colony characteristics of these isolates were consistent with previous descriptions of R. solanacearum (Kelman, 1954; She et al., 2012). All the isolates were pathogenic in C. maxima after artificial inoculation in the greenhouse, and they caused wilt symptoms similar to those observed in the field (Figure 1). The same pathogens were re-isolated from the inoculated diseased plants. The 16S rRNA gene sequences from these isolates, which were identical to each other, shared 100% identity with the R. solanacearum strain GMI1000 sequence from the GenBank database. According to the sizes of Pmx- and phylotype I-specific PCR products, these isolates were also identified to be R. solanacearum.
All of the R. solanacearum isolates from C. maxima in this study produced typical R. solanacearum-type colonies that were irregular, round, fluidal, and white with a pink center on TZC medium plates (Figure 2). However, eight isolates secreted a brown pigment (Figure 2B). According to their carbohydrate utilization patterns, all of the isolates that produced brown pigment were classified as biovar 4. Interestingly, we also isolated seven brown pigment-producing strains from Z. officinale that also belong to biovar 4 (unpublished data). The purpose of brown pigment production by R. solanacearum is unclear. Previous studies of R. solanacearum biovars from other hosts have shown that biovars 3 and 4 are dominant biovars in Guangdong (Zeng and Dong, 1995), consistent with this study. Biovars 3 and 4 were isolated from C. maxima, while biovars 1, 2, and 5 were not.
Virulence differentiation of R. solanacearum from C. maxima in different hosts was observed in this study. All of the isolates from C. maxima were highly virulent to S. lycopersicum and S. melongena, weakly virulent to C. annuum and N. tabacum and avirulent to M. nana. Six of eight biovar 3 isolates were weakly virulent to Z. officinale, whereas 16 biovar 4 isolates and two biovar 3 isolates, RS362 and RS366 were avirulent to Z. officinale. Based on their wide host range that includes four solanaceous crops, S. lycopersicum, S. melongena, C. annuum, and N. tabacum (Table 2), the twenty-four isolates were all classified into race 1, indicating they are quite different from a strain that was isolated from C. maxima in Colombia, which was classified as race 2 (Romo et al., 2012). The Pmx- and phylotype I-specific PCR and phylogenetic analysis (Figures 3, 4) results illustrated that the 24 isolates belong to phylotype I. Thus, the R. solanacearum isolates from C. maxima in this study belong to phylotype I, race 1, and biovar 3 or 4; this finding is consistent with the latest hierarchical classification scheme proposed by Fegan and Prior (2005) in which all R. solanacearum isolates from Asia are phylotype I (race 1: bv 3, 4, and 5).
Phylotype I is the lineage with the highest evolutionary divergence among the four phylotypes of R. solanacearum. Phylogenetic analysis of the egl and hrpB genes revealed that the 24 isolates of R. solanacearum from C. maxima clustered into three sequevars, including sequevars 17, 45, and 56 (Figure 3). Among these three sequevars, only sequevar 17 has been reported to infect S. lycopersicum, S. melongena, C. annuum, N. tabacum, Solanum tuberosum, and Pogostemon cablin in China (Xu et al., 2009; She et al., 2012). Sequevar 45 has not been previously described in China. Sequevar 56, the isolates of which clustered in a unique clade based on phylogenetic analysis of the egl gene, is a novel sequevar (Figure 3). Novel sequevars may result from the continuous evolution of phylotype I strains, which enables them to develop a wide host range and to adapt to extreme environments, providing virulence plasticity (Liu et al., 2017).
Planting resistant cultivars is effective and the simplest method for controlling bacterial wilt (Wang et al., 1998). In this study, variation analysis of the resistance of pumpkin cultivars to R. solanacearum strain RS378 showed that two C. moschata cultivars, Xiangyu1 and Xiangmi, were resistant or moderately resistant to strain RS378, but the 15 other C. moschata cultivars were highly susceptible or susceptible. Four C. maxima cultivars were all highly susceptible to strain RS378. Because of the limited number of cultivars of C. maxima used in this study, determining whether there are cultivars of C. maxima that are resistant to R. solanacearum is difficult. More pumpkin varieties must be collected and further evaluated for R. solanacearum resistance.
Ralstonia solanacearum is pathogenic on more than 200 plant species belonging to over 50 botanical families worldwide (Genin and Denny, 2012), and more host plants will be identified through surveys of R. solanacearum. In Guangdong, where temperatures are high (over 30°C) for approximately half the year, serious bacterial wilt disease often occurs. During the past ten years, seven new host plants, Ipomoea aquatic, Canna generalis, Hedychium coronarium, Zinnia elegans, Solidago canadensis, Pogostemon cablin, and Ageratum conyzoides, have been reported to be infected by R. solanacearum in Guangdong, China (He et al., 2008; Liu et al., 2009; She et al., 2012, 2013). In this paper, we report that R. solanacearum race 1 can infect C. maxima plants and cause wilt disease. Romo et al. (2012) reported that a R. solanacearum strain belonging to race 2 was isolated from C. maxima in Colombia, but we could not obtain further information on the biovar, sequevar, or phylotype of the strain or its pathogenicity and virulence attributes in C. maxima or other Solanaceae plants. To the best of our knowledge, this is the first report of bacterial wilt caused by R. solanacearum race 1 in C. maxima in the world.
Conclusion
Bacterial wilt disease in C. maxima in Guangdong, China, is caused by R. solanacearum. All 24 strains isolated from C. maxima in this study belong to phylotype I, race 1 and biovar 3 or 4. These isolates clustered into sequevars 17, 45, and 56. Sequevar 45 was identified in China for the first time in this study, and sequevar 56 is a novel sequevar that has not been described previously. This study is the first report to identify R. solanacearum race 1 infections in C. maxima. Two C. moschata cultivars, Xiangyu1 and Xiangmi, were resistant or moderately resistant to R. solanacearum strain RS378. Our results provide valuable information for the further development of control strategies for C. maxima wilt disease.
Author Contributions
All authors made a substantial, direct and intellectual contribution to the work; XS wrote the original draft, and ZH revised the manuscript.
Funding
This work was supported by the Science and Technology program of Guangdong, China (2015B020203002, 2015A020209057, and 2014B020202004; “The Construction of Green Management R&D Center for Crop Pests in Guangdong Province”), and the Foundation of the President of Guangdong Academy of Agricultural Sciences of China (201513).
Conflict of Interest Statement
The authors declare that the research was conducted in the absence of any commercial or financial relationships that could be construed as a potential conflict of interest.
References
Buddenhagen, I., Sequeira, L., and Kelman, A. (1962). Designation of races in Pseudomonas solanacearum. Phytopathology 52:726.
Castillo, J. A., and Greenberg, J. T. (2007). Evolutionary dynamics of Ralstonia solanacearum. Appl. Enviro. Microbiol. 73, 1225–1238. doi: 10.1128/AEM.01253-06
Cook, D., Barlow, E., and Sequeira, L. (1989). Genetic diversity of Pseudomonas solanacearum: detection of restriction fragment length polymorphisms with DNA probes that specify virulence and the hypersensitive response. Mol. Plant. Micro. Int. 2, 113–121. doi: 10.1094/MPMI-2-113
Cook, D., and Sequeira, L. (1994). “Strain differentiation of Pseudomonas solanacearum by molecular genetic methods,” in Bacterial Wilt: The Disease and Its Causative Agent, Pseudomonas solanacearum, ed. A. C. Hayward and G. L. Hartman (Wallingford, UK: CAB International l), 77–93.
Denny, T. (2006). “Plant pathogenic Ralstonia species,” in Plant-Associated Bacteria, ed. S.S. Gnanamanickam (Dordrecht: Springer), 573–644.
Fegan, M., and Prior, P. (2005). “How complex is the Ralstonia solanacearum species complex,” in Bacterial wilt disease and the Ralstonia solanacearum species complex, ed. C. Allen, P. Prior and A. C. Hayward (St. Paul, MN: APS), 449–462.
Fegan, M. and Prior, P. (2006). Diverse members of the Ralstonia solanacearum species complex cause bacterial wilts of banana. Aust. Plant Pathol. 35, 93–101. doi: 10.1071/AP05105
Fegan, M., Taghavi, M., Sly, L. I., and Hayward, A. C. (1998). “Phylogene, diversity and molecular diagnostics of Ralstonia solanacearum,” in Bacterial Wilt Disease: Molecular and Ecological Aspects, eds P. Prior, C. Allen and J. Elphinstone (Berlin; Heidelberg: Springer), 19–33.
Gabriel, M. S. T., Cellie, G., Guilbaud, C., Kahane, R., Allen, C., and Prior, P. (2009). Broad diversity of Ralstonia solanacearum strains in Cameroon. Plant Dis. 93, 1123–1130. doi: 10.1094/PDIS-93-11-1123
Genin, S., and Denny, T. P. (2012). Pathogenomics of the Ralstonia Solanacearum species complex. Ann. Rev. Phytopathol. 50, 67–89. doi: 10.1146/annurev-phyto-081211-173000
Hall, T. A. (1999). BioEdit: a user-friendly biological sequence alignment editor and analysis program for Windows 95/98/NT. Nucleic Acids Symp. Ser. 41, 95–98.
Hayward, A. C. (1964). Characteristics of Pseudomonas solanacearum. J. Appl. Bacteriol. 27, 265–277. doi: 10.1111/j.1365-2672.1964.tb04912.x
Hayward, A. C. (1991). Biology and epidemiology of bacterial wilt caused by Pseudomonas solanacearum. Ann. Rev. Phytopathol. 29, 65–87. doi: 10.1146/annurev.py.29.090191.000433
Hayward, A. C. (1994). “Systematics and phylogeny of Pseudomonas solanacearum and related bacteria,” in Bacterial Wilt: The Disease and Its Causative Agent, Pseudomonas solanacearum, eds A. C. Hayward and G. L. Hartman (Wallingford, UK: CAB International), 123–135.
He, L. Y. (1985). “Bacterial wilt in the People's Republic of China,” in Bacterial Wilt Disease in Asia and the South Pacific, ed G. J. Perley (Canberra: Proceedings of an international workshop held at PCARRD), 40–48.
He, L. Y., Sequeira, L., and Kelman, A. (1983). Characteristics of strains of Pseudomonas solanacearum. Plant Dis. 67, 1357–1361. doi: 10.1094/PD-67-1357
He, Z. F., She, X. M., Yu, H., Luo, F. F., and LI, H. P. (2008). Pathogen identification of bacterial wilt of Ipomoea aquatic. Acta Phytopathol. Sin. 38, 120–125. doi: 10.3321/j.issn:0412-0914.2008.02.002
Kelman, A. (1954). The relationship of pathogenicity in Pseudomonas solanacearum to colony appearance on a tetrazolium medium. Phytopathology 44, 693–695.
Li, X., Dorsch, M., Del Dot, T., Sly, L. I., Stackebrandt, E., and Hayward, A. C. (1993). Phylogenetic studies of the rRNA group II pseudomonads based on 16S rRNA gene sequences. J. Appl. Bacteriol. 74, 324–329. doi: 10.1111/j.1365-2672.1993.tb03032.x
Li, Y. Y., Feng, J., Liu, H. L., Wang, L., Hsiang, T., Li, X. H., et al. (2016). Genetic diversity and pathogenicity of Ralstonia solanacearum causing tobacco bacterial wilt in China. Plant Dis. 100, 1288–1296. doi: 10.1094/PDIS-04-15-0384-RE
Lin, C. H., Tsai, K. C., Prior, P., and Wang, J. F. (2014). Phylogenetic relationships and population structure of Ralstonia solanacearum isolated from diverse origins in Taiwan. Plant Pathol. 63, 1395–1403. doi: 10.1111/ppa.12209
Liu, Q. G., Zeng, W. D., Zheng, X. H., and Che, Z. P. (2009). Identification of pathogenic bacteria from four species of flowering plants. J. Huazhong Agri. Univ. 28, 277–280. doi: 10.3321/j.issn:1000-2421.2009.03.006
Liu, Y., Wu, D. S., Liu, Q. P., Zhang, S. T., Tang, Y. M., Jiang, G. F., et al. (2017). The sequevar distribution of Ralstonia solanacearum in tobacco-growing zones of China is structured by elevation. Eur. J. Plant Pathol. 147, 541–551. doi: 10.1007/s10658-016-1023-6
Opina, N., Tavner, F., Hollway, G., Wang, J. F., Li, T. H., Maghirang, R., et al. (1997). A novel method for development of species and strain-specific DNA probes and PCR primers for identifying Burkholderia solanacearum. Asia Pacific J. Mol. Biol. Biotechnol. 5, 19–30.
Pegg, K. G., and Moffett, M. (1971). Host range of the ginger strain of Pseudomonas solanacearum in Queensland. Aust. J. Exp. Agric. Anim. Hus. 11, 696–698. doi: 10.1071/EA9710696
Poussier, S., Prior, P., Luisetti, J., Hayward, C., and Fegan, M. (2000b). Partial sequencing of the hrpB and endoglucanase genes confirms and expands the known diversity within the Ralstonia solanacearum species complex. Syst. Appl. Microbiol. 23, 479–486. doi: 10.1016/S0723-2020(00)80021-1
Poussier, S., Trigalet-Demery, D., Vandewalle, P., Goffinet, B., Luisetti, J., and Trigalet, A. (2000a). Genetic diversity of Ralstonia solanacearum as assessed by PCR-RFLP of the hrp gene region, AFLP and 16S rRNA sequence analysis and identification of an African subdivision. Microbiology 146, 1679–1692. doi: 10.1099/00221287-146-7-1679
Prior, P., Ailloud, F., Dalsing, L. B., Remenat, B., Sanchez, B., and Allen, C. (2016). Genomic and proteomic evidence supporting the division of the plant pathogen Ralstonia solanacearum into three species. BMC Genomics 17:90. doi: 10.1186/s12864-016-2413-z
Prior, P., and Fegan, M. (2005). Recent development in the phylogeny and classification of Ralstonia solanacearum. Acta Hortic. 695, 127–136. doi: 10.17660/ActaHortic.2005.695.14
Romo, J. P., Osorio, J. G. M. II, and Yepes, M. S. (2012). Identification of new hosts for Ralstonia solanacearum (Smith) race 2 from Colombia. Rev. Proteccion Veg. 27, 51–161. Available online at: http://scielo.sld.cu/scielo.php?script=sci_arttext&pid=S1010-27522012000300003&lng=en&tlng=en
Safni, I., Cleenwerck, I., Vos, D. P., Fegan, M., Sly, L., and Kappler, U. (2014). Polyphasic taxonomic revision of the Ralstonia solanacearum species complex: proposal to emend the descriptions of Ralstonia solanacearum and Ralstonia syzygii and reclassify current R. syzygii strains as Ralstonia syzygii subsp. syzygii subsp. nov., R. solanacearum phylotype IV strains as Ralstonia syzygii subsp. indonesiensis subsp. nov., banana blood disease bacterium strains as Ralstonia syzygii subsp. celebesensis subsp. nov. and R. solanacearum phylotype I and III strains as Ralstonia pseudosolanacearum sp. nov. Int. J. Syst. Evol. Microbiol. 64, 3087–3103. doi: 10.1099/ijs.0.066712-0
She, X. M., He, Z. F., and Luo, F. F. (2012). Pathogen identification of Pogostemon cablin bacterial wilt in Guangdong. Acta Phytopathol. Sin. 42, 569–576. doi: 10.13926/j.cnki.apps.2012.06.003
She, X. M., He, Z. F., and Luo, F. F. (2013). Pathogen identification of Ageratum conyzoides bacterial wilt disease and its biological characteristics. Acta Phytophyl. Sin. 40, 533–539. doi: 10.13802/j.cnki.zwbhxb.2013.06.001
Taghavi, M., Hayward, A. C., Sly, L. I., and Fegan, M. (1996). Analysis of the phylogenetic relationships of strains of Burkholderia solanacearum, Pseudomonas syzygii, and the Blood Disease Bacterium of banana based on 16S rRNA gene sequences. Int. J. Syst. Bacteriol. 46, 10–15. doi: 10.1099/00207713-46-1-10
Tamura, K., Stecher, G., Peterson, D., Filipski, A., and Kumar, S. (2013). MEGA6: molecular evolutionary genetics analysis version 6.0. Mol. Biol. Evol. 30, 2725–2729. doi: 10.1093/molbev/mst197
Wang, J. F., Hanson, P., and Barnes, J. A. (1998). “Worldwide Evaluation of an International set of resistance sources to bacterial wilt in tomato.” in Bacterial Wilt Disease, ed. P. Prior, C. Allen and J. Elphinstone (Berlin; Heidelberg: Springer), 269–275.
Wang, T., Lin, W., Huang, Y. L., Yuan, G. Q., and Li, Q. Q. (2009). Identification of the pathogen of Siraitia grosvenorii wilt. Acta Phytopathol. Sin. 39, 318–320. doi: 10.3321/j.issn:0412-0914.2009.03.016
Wicker, E., Lefeuvre, P., de Cambiaire, J. C., Lemaire, C., Poussier, S., and Prior, P. (2012). Contrasting recombination patternas and demographic histories of the plant pathogen Ralstonia solanacearum inferred from MLSA. ISME J. 6, 961–974. doi: 10.1038/ismej.2011.160
Woese, C. R., Gutell, R., and Noller, H. F. (1983). Detailed analysis of the higher-order structure of 16S-like ribosomal ribonucleic acids. Microbiol. Rev. 47, 621–669.
Xu, J., Pan, Z. C., Prior, P., Xu, J., Zhang, Z., Zhang, H., et al. (2009). Genetic diversity of Ralstonia solanacearum strains from China. Eur. J. Plant Pathol. 125, 641–653. doi: 10.1007/s10658-009-9512-5
Keywords: Ralstonia solanacearum, identification, bacterial wilt, Cucurbita maxima, phylotype I, sequevar
Citation: She X, Yu L, Lan G, Tang Y and He Z (2017) Identification and Genetic Characterization of Ralstonia solanacearum Species Complex Isolates from Cucurbita maxima in China. Front. Plant Sci. 8:1794. doi: 10.3389/fpls.2017.01794
Received: 28 March 2017; Accepted: 02 October 2017;
Published: 18 October 2017.
Edited by:
Nemo Peeters, Institut National de la Recherche Agronomique de Toulouse, FranceReviewed by:
Munusamy Madhaiyan, Temasek Life Sciences Laboratory, SingaporeCyril Jourda, Centre de Coopération Internationale en Recherche Agronomique pour le Développement (CIRAD), France
Copyright © 2017 She, Yu, Lan, Tang and He. This is an open-access article distributed under the terms of the Creative Commons Attribution License (CC BY). The use, distribution or reproduction in other forums is permitted, provided the original author(s) or licensor are credited and that the original publication in this journal is cited, in accordance with accepted academic practice. No use, distribution or reproduction is permitted which does not comply with these terms.
*Correspondence: Zifu He, aGV6ZkBnZHBwcmkuY29t